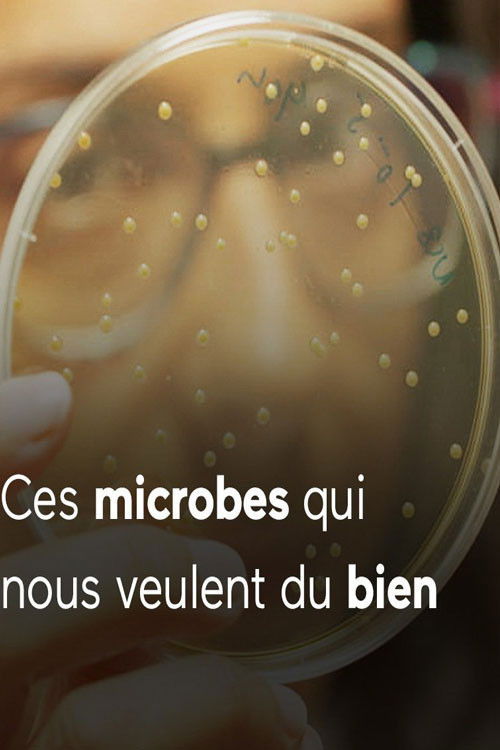
Ces microbes qui vous veulent du bien

Resultados de búsqueda: "microbe"
Encontramos 20 coincidencias para tu búsqueda

FR
6.1
Microbe et Gasoil
2015Movie

FR
10.0
Ces microbes qui nous gouvernent
2016Movie

EN
6.0
Microbes and Men
1974TV

FR
4.5
Les joyeux microbes
1909Movie

FR
10.0
Vive les microbes !
2024Movie

FR
8.0
Pasteur et Koch : Un duel de géants dans la guerre des microbes
2018Movie
EN
0.0
The Microbe Army
1935Movie

FR
5.0
La Peur des microbes
1907Movie
EN
0.0
Microbes Rule the World
2006Movie
FR
0.0
Ces microbes qui vous veulent du bien
N/AMovie
FR
0.0
les microbes
2024Movie

EN
0.0
Microbes
1990Movie

FR
0.0
L'abobinable microbe
1992Movie

EN
0.0
The Microbe
1919Movie
EN
4.0
The Unclean World
1903Movie

EN
9.0
Bacterial World
2016Movie

CS
0.0
Mikrob
1986Movie
CS
0.0
Lovci mikrobů
2021Movie

RU
6.0
Одинокие души микробов
2014Movie

EN
0.0
All Creatures Great & Small
2010Movie